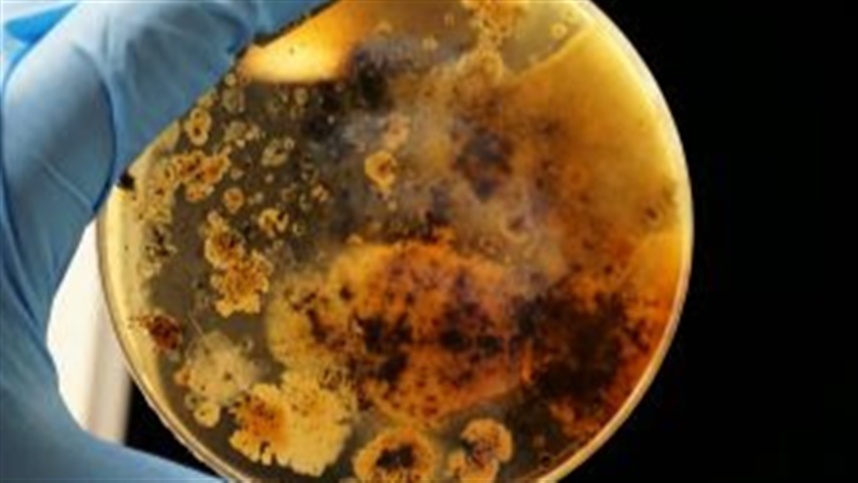

Biológicos ampliam a eficiência nutricional no campo
Bioinsumos podem gerar uma economia de até US$ 5,1 bilhões anuais
Foto: Divulgação
Foto: Divulgação
A integração de produtos biológicos ao manejo de sistemas agrícolas marca um passo importante para o futuro do agronegócio. Na busca por maior produtividade aliada a práticas mais sustentáveis, o uso desse tipo de insumo cresce a cada ano. Segundo levantamento da FGVAgro, a área tratada com bioinsumos no Brasil cresceu 50% na safra de 2023/2024, na comparação com 2021/2022. Formulados a partir de microrganismos que promovem o crescimento das plantas, otimizam a absorção de nutrientes e oferecem proteção contra pragas e patógenos, os biológicos têm se consolidado como ferramentas estratégicas para elevar a produtividade agrícola, ao mesmo tempo em que reduzem a dependência de insumos químicos.
Os biológicos desempenham papel crucial na eficiência nutricional e no desempenho produtivo das culturas. Microrganismos como as bactérias fixadoras de nitrogênio ou facilitadoras da absorção de fósforo aumentam a capacidade das plantas de assimilar macro e micronutrientes essenciais e, em alguns casos, reforçam mecanismos naturais de proteção contra pragas e doenças. Isso se traduz em cultivares mais saudáveis e com melhor qualidade para consumo humano e animal. “Os produtos biológicos representam um avanço significativo na agricultura moderna. Eles permitem maior aproveitamento de nutrientes como nitrogênio e fósforo pelas plantas, ao mesmo tempo em que reduzem a necessidade de insumos químicos. No Brasil, onde mais da metade dos custos operacionais do produtor está ligada à compra de insumos químicos importados, como fertilizantes e defensivos agrícolas, oferecer soluções sustentáveis como estas significa reduzir gastos, ampliar a competitividade do agronegócio e abrir caminho para uma agricultura mais eficiente e resiliente.”, destaca Rafael de Souza, CEO e cofundador da Symbiomics, empresa brasileira de biotecnologia dedicada ao desenvolvimento de produtos biológicos de alto desempenho para a agricultura.
Além dos ganhos em produtividade, outros benefícios também têm sido comprovados pela ciência. Um estudo publicado no Europe PMC demonstrou que a utilização de bioinsumos eleva a qualidade nutricional de frutas e hortaliças ao aumentar níveis de compostos antioxidantes (antocianinas, flavonóides, carotenóides), além de elevar os teores de minerais e clorofila. Já uma pesquisa realizada na China e publicada na revista Agriculture apontou que o uso de biofertilizantes elevou, em média, o teor de vitamina C em 14,6% e de proteína em 16,6% na maioria das culturas analisadas no país.
Resiliência e sustentabilidade
Embora estejam presentes no Brasil desde os anos 1950, os produtos biológicos foram, por muito tempo, baseados em poucas espécies. Segundo o Ministério da Agricultura e Pecuária (MAPA), entre 2020 e 2024 foram registrados 631 novos inoculantes, o que corresponde a aproximadamente 87% do total atualmente disponível no país. No Brasil, já estão aprovados 737 produtos, dos quais cerca de 62% são à base de microrganismos do gênero Bradyrhizobium. Outros 10% utilizam cepas de Azospirillum brasilense, reforçando o predomínio de poucas espécies no mercado brasileiro. O cenário é semelhante no segmento de produtos para biocontrole, onde também se observa uma concentração em torno de determinados grupos microbianos. Nesse sentido, a Symbiomics aposta na diversificação do portfólio do setor ao pesquisar novos microrganismos que tenham múltiplas aplicações, prospectados da biodiversidade brasileira.
A adoção de produtos biológicos também possui forte impacto ambiental. A fixação biológica de nitrogênio em leguminosas, como soja e feijão, reduz drasticamente a dependência de fertilizantes nitrogenados sintéticos, diminuindo custos de produção e emissões de gases de efeito estufa. O Brasil é hoje referência mundial nesse campo: a inoculação da soja com bactérias do gênero Bradyrhizobium já cobre quase 90% da área cultivada, com mais de 150 milhões de doses aplicadas por safra, substituindo o uso de fertilizantes nitrogenados químicos em larga escala. Esse é um dos fatores que contribuem para a elevada competitividade da soja brasileira no mercado internacional.
Enquanto a FBN em leguminosas já se consolidou como uma tecnologia de sucesso, a aplicação em gramíneas, como milho, trigo e cana-de-açúcar, ainda representa uma fronteira de inovação. Nessas culturas, a associação com microrganismos promotores de crescimento e solubilizadores de nutrientes pode ampliar de forma expressiva o potencial de uso dos bioinsumos. Segundo um estudo estratégico publicado em 2024 pelo Ministério da Agricultura e Pecuária, em parceria com o setor privado, estima que a adoção de bioinsumos em gramíneas poderia gerar uma economia de até US$ 5,1 bilhões anuais para o agronegócio brasileiro, além de reduzir até 18,5 milhões de toneladas de emissões de CO2 ao substituir os fertilizantes tradicionais.
“O agronegócio brasileiro enfrenta hoje o desafio de manter altas produtividades ao mesmo tempo em que precisa reduzir a dependência de insumos químicos e responder às crescentes demandas por sustentabilidade. É nesse contexto que os biológicos ganham protagonismo, oferecendo alternativas mais eficientes e com menor impacto ambiental. Por isso, mais do que novos produtos, a Symbiomics surge justamente para acelerar essa transição: nosso compromisso é desenvolver soluções que aumentem a produtividade do agricultor de forma sustentável, reduzindo a dependência de químicos e contribuindo para uma agricultura mais regenerativa”, completa Jader Armanhi, COO e cofundador da empresa.
Desse modo, a tecnologia é aliada principal para o avanço e a diversificação desse mercado. Dentro desse cenário, a Symbiomics se destaca nesse mercado por aplicar estudo de microbioma, sequenciamento genômico, inteligência artificial e edição de genoma na descoberta e desenvolvimento de microrganismos robustos com múltiplos modos de ação, a partir de uma coleção proprietária formada pela biodiversidade brasileira. Sua plataforma tecnológica permite isolar e analisar, de maneira rápida e precisa, milhares de cepas microbianas, identificando aquelas com maior potencial de promover nutrição, bioestímulo, biocontrole e até sequestro de carbono. Recentemente, a empresa anunciou parcerias importantes com empresas como Nitro e Stoller, e concluiu uma rodada de financiamento Série A, liderada pela Corteva Catalyst, junto com Arar Capital, Cazanga, MOV Investimentos e The Yield Lab Latam. Esse movimento reforça sua posição de liderança no setor de biotecnologia e abre caminho para a expansão de suas soluções no Brasil e no mundo.


